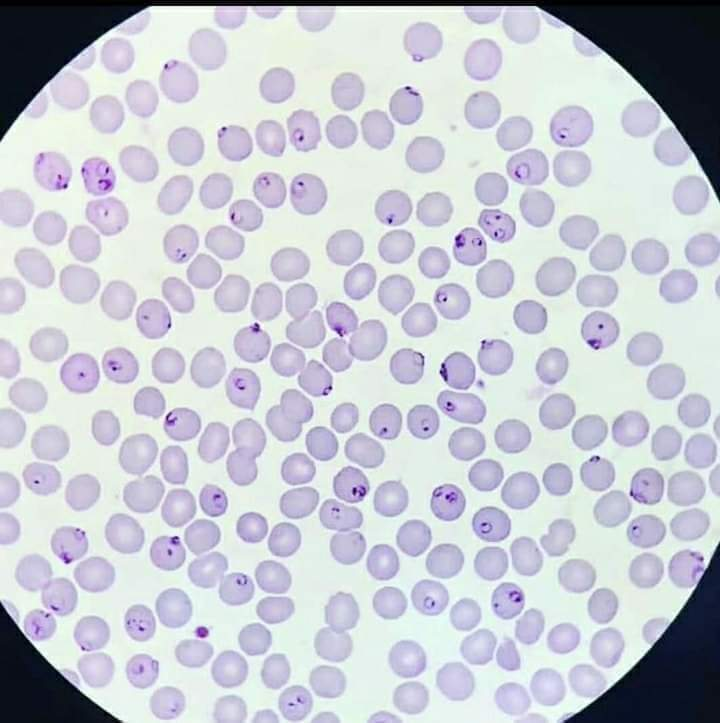
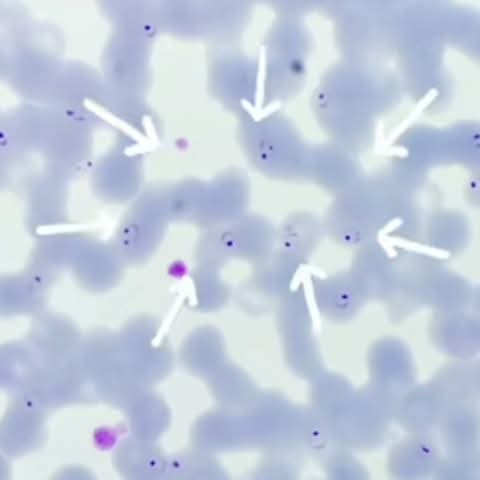
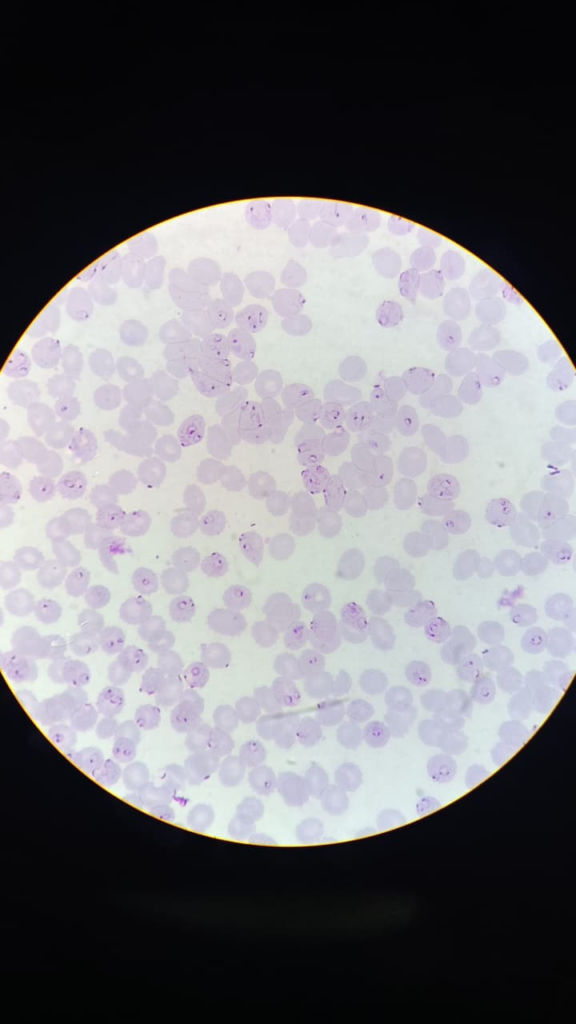
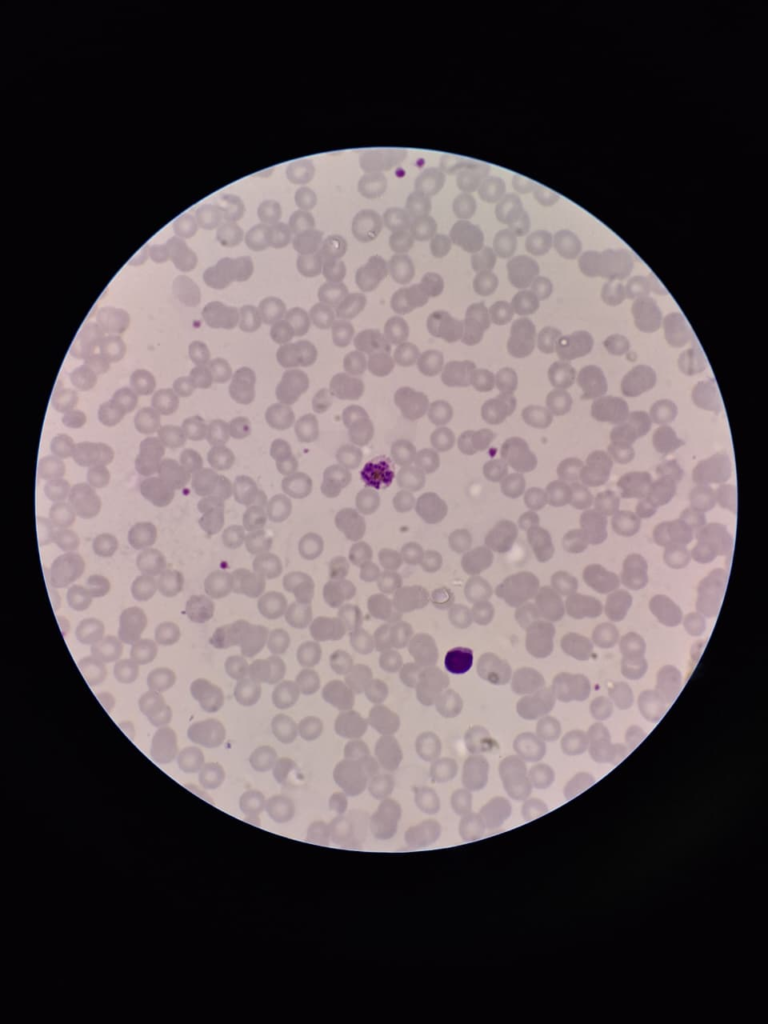
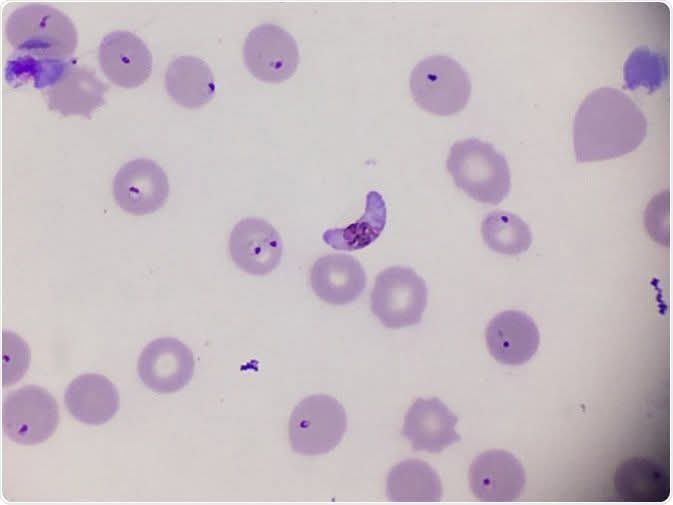

Morphology of Plasmodium Falciparum
Plasmodium falciparum was discovered by Welch in 1897. It is found only in human beings. It is also called malignant tertian malaria or pernicious malaria.
- Malignant means dangerous.
- “Tertian” means the fever occurs every 36 to 48 hours.
In P. falciparum infection, the commonest asexual forms of the parasite detectable in peripheral circulation are rings, gametocytes, and sometimes early trophozoites. Multiple infections may occur, i.e., two or more rings can be present in a single RBC.
In P. falciparum infection, growth occurs in blood vessels supplying internal organs such as the kidney, brain, lungs, liver, and heart. In cerebral malaria, when rings attack infected RBCs, fibrin is secreted, causing RBCs to collapse and blood vessels to become blocked.

1) Ring Stage

- A single ring occupies about one-fifth to one-sixth of the RBC.
- It has a red chromatin with a thin, hair-like cytoplasm.
- Various shapes of rings may be seen in thick and thin blood smears, such as comma-shaped, exclamation mark-shaped, or wing-shaped.
2) Trophozoite Stage
- Cytoplasm is regular, and chromatin is small and compact.
- Pigments are black in color and situated opposite to the chromatin.
- In P. falciparum, stipplings known as Maurer’s dots are seen around the cytoplasm.
3) Mature Schizont
- Merozoites with small chromatin are surrounded by cytoplasm, numbering 8 to 32.
- In this stage, black pigment is grouped at the center.
4) Male Gametocyte (Microgametocyte)
- Male gametocytes of P. falciparum are crescent- or banana-shaped.
- They have blunt edges, with chromatin diffused in the center of the cytoplasm.
- Pigments are black in color.
- The male gametocyte is smaller than the female gametocyte.
5) Female Gametocyte (Macrogametocyte)
- Female gametocytes are crescent-shaped with sharp edges.
- They are larger than male gametocytes.
- Compact chromatin is present at the center, surrounded by cytoplasm.
- Black pigment is present near the chromatin.



